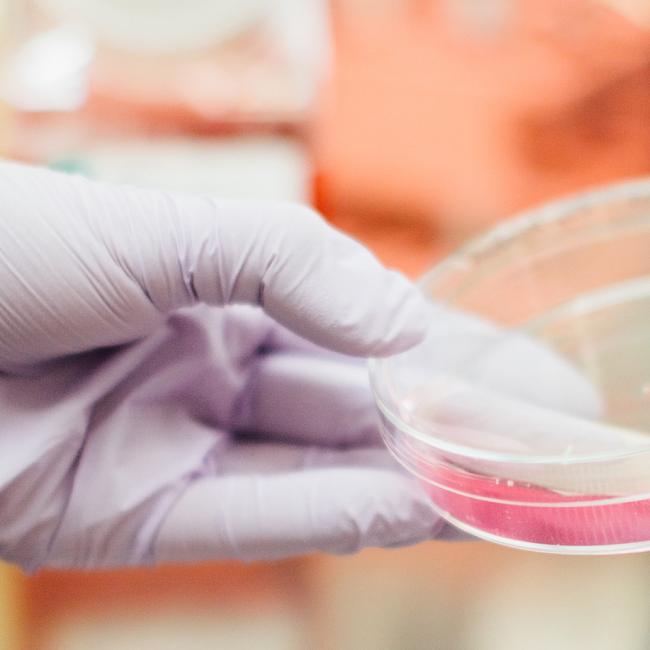

Contact us to request a quote
Boral Australia is a major supplier of products and materials to the residential and commercial construction, and roads and engineering markets. As one of Australia's largest and most experienced construction materials suppliers, Boral has the resources and the expertise to perform for customers Australia wide.